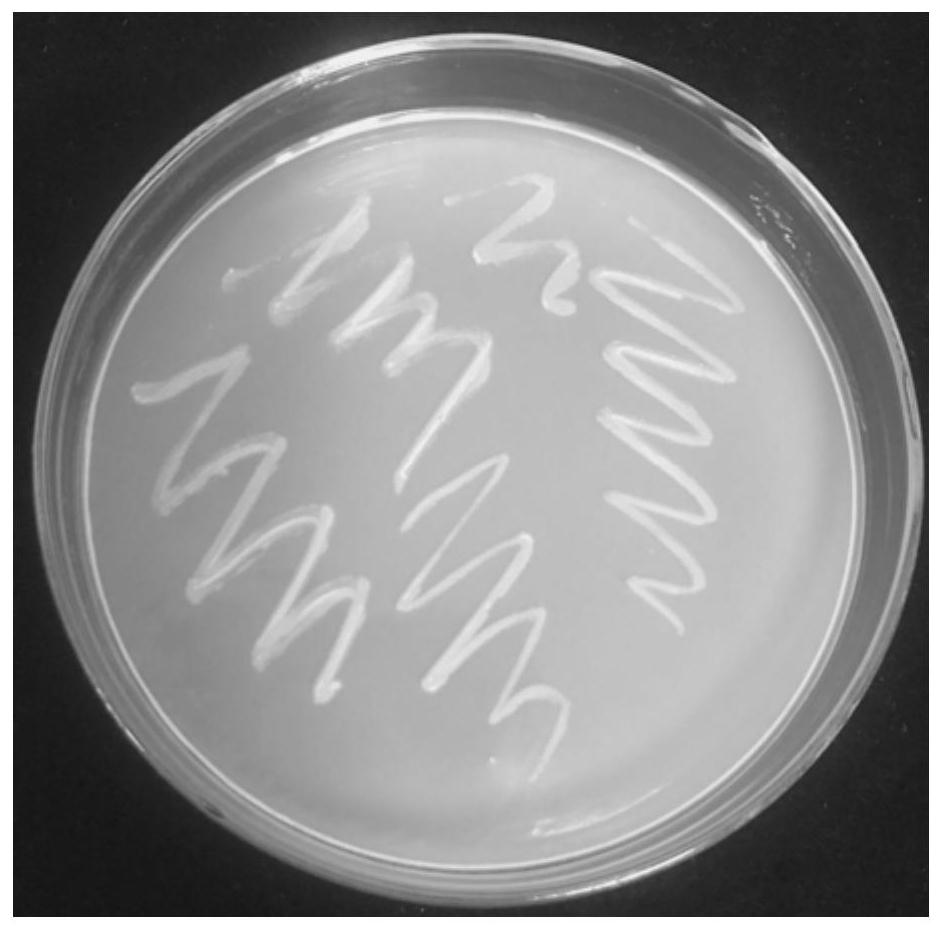
一株产几丁质酶的链霉菌及其应用

白色链霉菌图片

一种白色链霉菌x-18及利用该菌生产ε-聚赖氨酸的方法与流程
图片尺寸378x284
"白念"是白色念珠菌的简称很多人对白色念珠菌都不太熟悉,但如果说到
图片尺寸894x675
白色链霉菌
图片尺寸400x300
白色链霉菌
图片尺寸268x200
姐妹们这种白色的是霉菌吗有图谢谢
图片尺寸1080x810
白色霉菌孢子特写
图片尺寸800x533
请问下大家:无纺布上长的这白色的是什么霉,菌?恳请大家了!
图片尺寸4000x3000
白色念珠菌敲除某个基因后,"敲除株"菌落较野生株菌落形态变小,颜色变
图片尺寸719x1280
二,白色链孢霉一,橘色链孢霉现在危害食用菌生产的链孢霉主要有如下
图片尺寸1080x1439
这是什么霉菌
图片尺寸4160x2336
白色念珠菌03
图片尺寸442x322
同时模具特写,土壤上的白霉菌特写
图片尺寸1023x681
这是什么霉菌
图片尺寸4160x2336
白色念珠菌.jpg
图片尺寸1500x1125
链霉菌
图片尺寸400x343
白色念珠菌,镜检图片,原来显微镜下白念菌这样子的,革兰氏阳性菌
图片尺寸960x1280
一株产几丁质酶的链霉菌及其应用
图片尺寸943x931
白色念珠菌菌丝
图片尺寸446x354
黄色为金黄色葡萄球菌,白色为苏云金芽胞杆菌菌,红色为土壤中筛选所得
图片尺寸600x565
本发明涉及一株产聚赖氨酸的白色链霉菌及其应用属于微生物领域
图片尺寸699x687